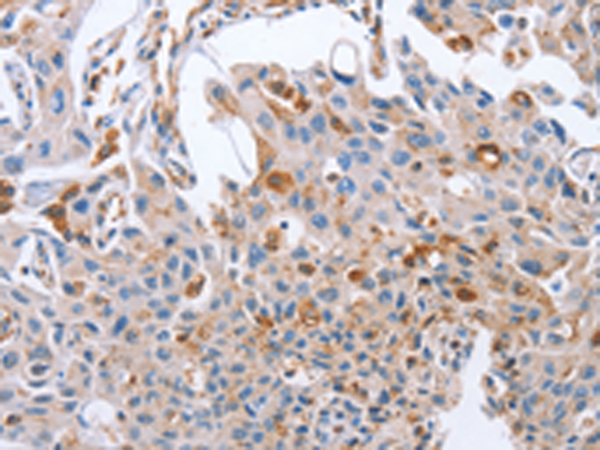
一抗

中文名稱: 兔抗NRG4多克隆抗體
英文名稱: Anti-NRG4 rabbit polyclonal antibody
別 名: HRG4
相關(guān)類別: 一抗
抗 原: NRG4
儲(chǔ) 存: 冷凍(-20℃)
宿 主: Rabbit
反應(yīng)種屬: Human, Mouse
標(biāo) 記 物: Unconjugate
克隆類型: rabbit polyclonal
技術(shù)規(guī)格
|
Background: |
Neuregulin 4 also known as NRG4 is a member of the neuregulin protein family which in humans is encoded by theNRG4 gene. Low affinity ligand for the ERBB4 tyrosine kinase receptor. Concomitantly recruits ERBB1 and ERBB2 coreceptors, resulting in ligand-stimulated tyrosine phosphorylation and activation of the ERBB receptors. Does not bind to the ERBB1, ERBB2 and ERBB3 receptors. |
|
Applications: |
ELISA, IHC |
|
Name of antibody: |
NRG4 |
|
Immunogen: |
Fusion protein of human NRG4 |
|
Full name: |
neuregulin 4 |
|
Synonyms: |
HRG4 |
|
SwissProt: |
Q8WWG1 |
|
ELISA Recommended dilution: |
1000-5000 |
|
IHC positive control: |
Human lung cancer and Human cervical cancer |
|
IHC Recommend dilution: |
50-200 |

 購(gòu)物車
購(gòu)物車 幫助
幫助
 021-54845833/15800441009
021-54845833/15800441009